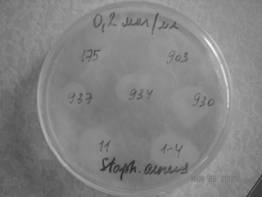
C:\Documents and Settings\Admin\��� ���������\����������� ������\��� ���������� ��� ���� 2009\DSC04324.JPG

Д.м.н. Холодок Г.Н.1, к.м.н. Стрельникова Н.В.2,
к.м.н. Ефименко1, М.В., к.м.н. Кольцов И.П.2, д.м.н. Козлов В.К. 1
Научно-исследовательский институт охраны
материнства и детства, Хабаровск1, Россия
Дальневосточный государственный медицинский университет,
Хабаровск2
Антилизоцимная активность оппортунистических бактерий в микробиоте
респираторного тракта у детей
Важным фактором
колонизации и персистирования возбудителя в организме хозяина является
продукция бактериями секретируемых субстанций, инактивирующих факторы
иммунитета. Лизоцим - один из ведущих факторов местного иммунитета [1]. Этот фермент обладает
бактерицидной активностью и присутствует
во многих клетках, тканях и секреторных жидкостях организма - в
лейкоцитах, слюне, слезной жидкости. Способность бактерий специфически
инактивировать лизоцим определяется как антилизоцимная активность. В литературе
указывается на преобладание антилизоцимной активности у грамотрицательных
бактерий и редкое выявление этого признака у грамположительных [2]. Антилизоцимная
активность (АЛА) выявляется у штаммов бактерий, вызывающих воспалительный процесс в тканях организма, то
есть определяют их инвазивную активность, а степень ее активности
свидетельствует
о патогенности микроорганизма и инвазивном потенциале бактерий.
Цель: выявить маркеры инвазивности штаммов
оппортунистических бактерий, колонизирующих микробиоту респираторного тракта у
детей.
Методы: Исследовали трахеальный аспират детей, больных
внебольничной пневмонией, госпитализированных в Клинику Института охраны
материнства и детства (1-я группа, n=973) и назофаренгиальные
мазки у здоровых детей (2-я группа, n=519), стандартными
микробиологическими методами в период 2002-2010 гг. Определяли спектр бактерий,
колонизирующих носоглотку, в том числе оппортунистических, способных вызывать
воспалительный процесс респираторного тракта. АЛА бактерий, потенциальных
возбудителей респираторной инфекции, определяли по О. В. Бухарину и соавт.
(1984) [1] у 89
штаммов изолированных бактерий. Собственную антагонистическую активность
бактерий изучали в модифицированном нами методе по выявлению АЛА. Лизоцим слюны
в % активности устанавливали фотонефелометрическим методом. Сравнили частоту
выявления и степень АЛА и собственную антагонистическую активность штаммов
микроорганизмов, изолированных из образцов в изучаемых группах пациентов.
Результаты и обсуждение. У штаммов
микроорганизмов, выделенных из клинических образцов (1-я группа ) установлена
высокая частота и повышенная степень АЛА. При постановке опыта с использованием
принципа «отсроченного антагонизма» в случае отсутствия роста тест-культуры M.lyzodecticus ATСС 2635 вокруг
исследуемого штамма результат a priori
расценивается как отрицательный результат наличия антилизоцимной активности и
наоборот наличие роста – как положительный результат (рис. 1).
251658240
Рис. 1. Рост тест-штамма M.lyzodecticus ATSS
2635 вокруг штаммов S.aureus, обладающих антилизоцимной активностью (концентрация
лизоцима в питательной среде 0.2 мкг/мл)
Наибольшую антилизоцимную активность выявляли у Staphylococcus spp.
- в 100% случаев с концентрацией 3,98±0,68 мкг/мл лизоцима в питательной
среде, меньшую активность - у Streptococcus spp. - в 99,1%. с
концентрацией лизоцима 3,05±0,89 мкг/мл и у штаммов Candida spp.
в 99,8% случаев с концентрацией лизоцима 2,83±0,46 мкг/мл.
Выявлено также достоверное повышение активности
лизоцима слюны у детей с внебольничной пневмонией (7,69±0,83 ед/мл/мин.) в
сравнении с показателями здоровых детей (3,96±0,03 ед/мл/мин.) (р=0,03), свидетельствующее об
однонаправленности этого процесса и увеличения АЛА клинических штаммов бактерий
(табл.1).
Таблица 1.
Активность
лизоцима слюны у детей с внебольничной пневмонией и у здоровых (M±m)
|
Группы наблюдения |
Активность лизоцима (ед/мл/мин) |
|
Внебольничная пневмония (n=37) |
7,69±0,83 |
|
Контроль (n=10) |
3,96±0,03 |
|
p |
0,03 |
У штаммов оппортунистических микроорганизмов,
выделенных из носоглотки у носителей установлены более низкая частота и уровни
АЛА. У 93% штаммов Staphylococcus spp. АЛА выявляли только
при низкой концентрации лизоцима в питательной среде - 0,93±0,73 мкг/мл,
у 76% штаммов Streptococcus spp. - при 2,14±0,22 мкг/мл, и только у 48% изолятов Candida spp.
При - 1,03±0,51 мкг/мл, и что свидетельствует об адаптации носоглоточных
штаммов к условиям колонизации.
Установлено отсутствие АЛА у 40% штаммов грамотрицательных бактерий, изолированных из
трахеального аспирата, что расходится с литературными данными о ее наличии у
90% грамотрицательных бактерий [ 3]. Это указывает на носоглоточное
происхождение значительной части штаммов, изолированных из трахеального
аспирата у детей с пневмонией, что может быть обусловлено некачественно
собранными для исследования образцами.
Кроме наличия АЛА, выявлено выделение опытными
штаммами собственных бактериоцинов, антагонистически влияющих на тест-культуру
микрококка (табл.2). Установили 4 степени антагонистической активности
микроорганизмов по отношению к микрококку: высокая – диаметр зоны задержки
роста микрококка ≥20 мм, средняя – 15-19 мм, низкая – 10-14 мм и
минимальная – до 10 мм. Среди бактерий с высоким уровнем бактерицидной
активности к микрококку чаще выявляли микроорганизмы, колонизирующие
носоглотку.
Таблица 2.
Уровни
антагонистической активности микроорганизмов по отношению к тест-штамму M.lyzodecticus ATSS 2635 (абс. / %±m)
|
Род/вид микроорганизмов |
Число
исследований (n) |
Степень активности |
||||
|
высокая |
средняя |
низкая |
минимальная |
отрицательная |
||
|
E.coli |
27 |
2/7,4±5,0 |
5/18,5±7,4 |
- |
- |
20/ 74,1±8,4 |
|
P.auruginosa |
8 |
4/50,0±17,7* |
- |
- |
- |
4/50,0±17,7 |
|
C.albicans |
9 |
6/66,7±15,7** |
- |
- |
- |
3/ 33,3±15,7 |
|
Enterobacter spp. |
6 |
2/33,3±19,2 |
- |
- |
- |
4/66,7±19,2 |
|
S.aureus |
29 |
- |
- |
3/10,3±5,6 |
13/44,8±9,2 |
13/44,8±9,2 |
|
Lactobacillus spp. |
6 |
3/50,0±20,4* |
- |
- |
- |
3/ 50,0±20,4 |
|
Всего |
85 |
17/20,0±4,3 |
5/5,9±2,6 |
3/3,5±2,0 |
13/15,3±3,9 |
47/55,3±5,3 |
Примечание. Различие достоверно в столбцах
с E.coli : * p<0,05; ** p<0,01
Антагонистическую
активность высокой степени по отношению к микрококку достоверно чаще (р<0,05) определяли у носоглоточных
штаммов P.auruginosa, C.albicans и Lactobacillus spp. - в 50,0±17,7% , 66,7±15,7% и 50,0±20,4% случаев
соответственно, чем у E coli – в 7,4±5,0% случаев. В данном случае вероятность принадлежности
штаммов E coli к инвазивным штаммам возрастает.
Таким образом,
показатели антилизоцимной активности оппортунистических микроорганизмов,
изолированных из респираторных образцов, выявляемые при концентрации лизоцима в
питательной среде от 3,98 до 2,83 мкг/мл могут являться маркерами инвазивной
активности оппортунистических микроорганизмов и, напротив, низкие – с
концентрацией лизоцима в питательной среде менее 2,14 мкг/мл, - маркерами носоглоточных изолятов, адаптированных к условиям колонизации в
микробиоте респираторного тракта.
Высокая степень антагонистической
активности по отношению к микрококку, комменсалу биотопа верхних дыхательных
путей, является маркером носоглоточного происхождения изолятов, полученных из
респираторных образцов.
Данные фенотипы были
использованы нами [4] для дифференциальной диагностики инвазивных и
неинвазивных штаммов оппортунистических микроорганизмов, выделенных из
респираторных образцов.
Литература:
1.
Бухарин О. В., Усвяцов Б. Я., Малышкин А. П. Метод определения
антилизоцимной активности микроорганизмов // Журн. микробиологии,
эпидемиологии и иммунобиологии. - 1984. - № 2. - С. 27-29.
2.
Бухарин О. В., Усвяцов Б. Я., Хуснутдинова , Л. М.
Межбактериальные взаимодействия //
Журн. микробиол. - 2003. - № 4. - С. 3-8.
3.
Механизмы выживания бактерий / О. В. Бухарин, А. Л.
Гинсбург, Ю. М. Романова, Г. И. Эль-Регистан. – М.: Медицина, 2005. – 367 с.
4.
Холодок Г.Н., Морозова Н.В., Козлов В.К.
Микробиологические и патогенетические аспекты внебольничной пневмонии у
детей.-Хабаровск, «Арно», 2013.-190 с.